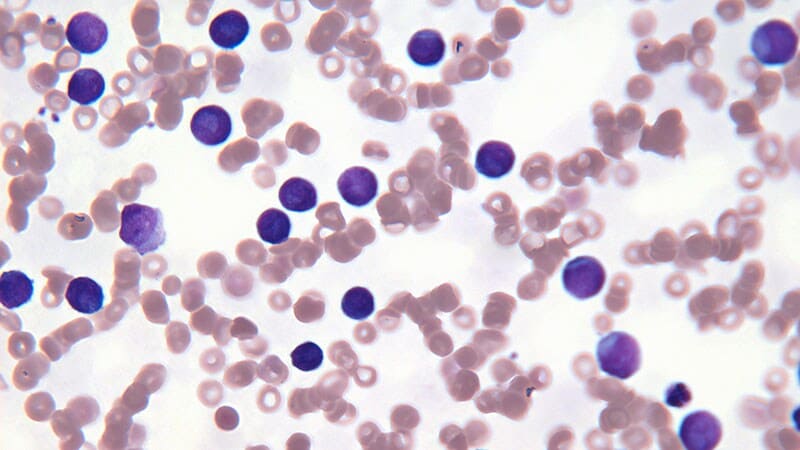

The Silent Assault: How Dioxins Infiltrate Your Body and How Nature Fights Back
Introduction: The Unseen Toxin in Your World You cannot see them, you cannot smell them, but they are there. A family of synthetic chemical poisons, known as dioxins, has woven itself into the fabric of our industrialized world. These contaminants are a …